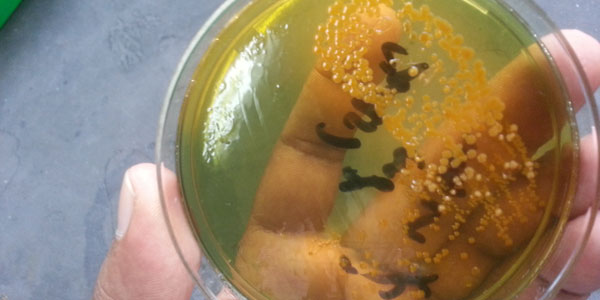
Study finds that flies can transmit cholera-causing pathogens. Africa carries the largest cholera burden, which is why an oral cholera vaccine trial is timeous.

Read More: ow.ly/x9hO50Y123V

#WitsForGood #WitsResearch #ResearchForGood

Zizwa
@zizwest
Principal @chitolirop
ID: 23421063
http://www.umpfest.com 09-03-2009 10:22:08
1,1K Tweet
712 Followers
413 Following











Nominations continue for 2025 #UMPAwards International Categories!Submit by Sept 15 👉 bit.ly/umpawards25 Ceremony in Oct during UMP Festival